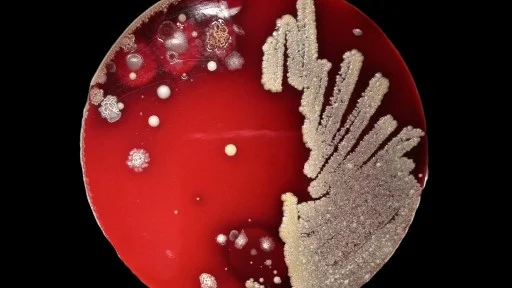
A petri dish with a red agar medium shows various colonies of bacteria growing, with dense streaks on the right and scattered colonies on the left.

This content is locked. Please login or become a member.


Within the span of a single generation, nearly every major civilization in the Mediterranean world collapsed simultaneously: the Hittites, the Mycenaeans, the Canaanites, the great palace cities of Cyprus and the Levant.
What is even more consequential than the age that preceeded it is what came next: a 400-year period that shaped the world as we know it today.
ERIC CLINE: I'm Eric Cline. I'm an archaeologist and an ancient historian. I'm also the author of 1177 BC, and it's sequel After 1177 BC. The period that we're discussing today is incredibly important in the history of humankind. It's the late Bronze Age, in particular, which goes from about 1700 to 1200 BCE, or BC, if you prefer. This was a time where people were basically globalized around the Mediterranean in a way that is not frequently seen. And so what happened to them back then may have implications for us today. So it turns out to be a much more important period to study than one might expect, even though it's more than 3,000 years ago.
The rise of a new world order.
One of the questions that I think is extremely relevant today comes in the sequel that I wrote, the after 1177 BC, which simply asks the question, what do you do if your society collapses? If the globalized network that you're a part of collapses, what do you do? How resilient are you? Now, resilience is a word that's bandied about today by lots of people. And that's part of the problem. It has different meanings for different people and in different situations. For me, resilience is how well you do in the face of adversity. How do you bounce back when something has gone wrong, sometimes very wrong? And I think there are basically three ways you can deal with it. And I get these from the IPCC, the Intergovernmental Panel on Climate Change. They won the Nobel Prize back in 2007. They are the ones that put out reports on climate change every year, every couple of years. And they put out something back in 2012 that was dealing with resilience and mitigation, what do you do after disasters? They're more looking at things like New Orleans after Hurricane Katrina, that kind of thing. But in that publication, they had some definitions that I thought fit very well with the late Bronze Age collapse and its aftermath. And what they say is that when you have such an event, there are basically three things you can do. You can either just try to survive until tomorrow, which basically means that you're coping. You're trying to make it until the sun comes up again. But you could also do a little bit more. You could adapt. You could be looking to next week or next month and just saying a little bit longer term survival. So coping is just tomorrow. Adapting is a little bit further out. But they also said there's a third thing. If you were to say, this can never happen again. We can't let New Orleans be flooded by the next hurricane. We have to transform. We have to do something about it. They said that's the top of the heap, basically. Yeah, you can cope. Yeah, you can adapt. If you transform, that's now where we're talking. And so I think that we can take a look at the G8 that was affected by the collapse and ask how well did each of them do? Did they simply cope? Did they adapt? Or did they go the extra mile and transform? Or did they do none of the above and they disappeared? So I think we can actually rank them and then try to ask, although this gets very difficult, try to ask what made each of them resilient or not? What made them be able to transform, cope, adapt or not? That's where it gets down into the nitty gritty and the weeds and it's kind of a, yeah, we might say that, but it's going to be hypothetical. But I think it's worth exploring because again, I think that's where we have lessons that might still be viable for us today. One of the things that we see in the aftermath of the collapse is basically a new world order. As each of the societies does or does not deal well in the aftermath, we can see new political systems popping up, for example. We can see new economic systems as they try and either grow back up from the ground like the Mycenaeans had to do and again, we don't have Mycenaean society after about 1050 BC. We now have the Greeks going back to ground zero and trying to build everything back up. In other places, the huge empires that had been around the Hittites, the Egyptians, Assyrians, Babylonians, some of them go away and are replaced by kind of a new world order. The Hittites, for example, up in Anatolia, they're replaced by smaller city-states and kingdoms. We've got some survivors whom we call the Neo-Hittites, the new Hittites in North Syria, but we've also got new groups, the Eartians, over in the eastern half of Turkey and the Frigens over in the western half of Turkey. They come on in and establish new, albeit smaller, kingdoms in the Iron Age. I think we see this especially though, down in the southern Levant, the area that today would be Israel, Palestinian territories, Jordan, part of Lebanon, because where we had the Canaanites in the Bronze Age and the Egyptian overlords, if you will, because the Egyptians basically ruled that area as part of their kingdom or empire, that all goes away at the end of the Late Bronze Age and it's replaced with much smaller city-states and kingdoms, which will sound familiar because we know them from the Hebrew Bible. We now have, after the collapse in the Iron Age, we now have the northern kingdom of Israel, the southern kingdom of Judah. We've got the kingdom of Edom, the kingdom of Moab, the kingdom of Ammon. All of these areas that we know from the biblical stories, they come into existence during these 400 years after the collapse, they are a reaction to what had just happened. And in fact, some scholars have suggested that maybe that's more than natural order of things, to have smaller city-states and smaller kingdoms, and that the empires of the Late Bronze Age were, as one person has put it, a failed experiment, that they tried and it didn't work all that well. I think I would disagree with that. I mean, that system survived for 500 years. I think that was pretty good, but it has no place now in the aftermath and we get all of these smaller city-states that are now flourishing. On the other hand, again, it's not all that cut and dried because what about the Assyrians and the Babylonians over in Mesopotamia? They're still there. They're now called the Neo-Assurians and the Neo-Babylonians, the new ones, but they have survived the collapse. Pretty much intact. They didn't do as well as the Phoenicians and the Cypriots, who I would give a gold star rating to, number one in my book, but I would give the Assyrians and Babylonians number two. They adapted. They almost kind of sort of transformed, but at least adapted. They've still got their government. They've still got writing. They're still writing. They've still got their religion. They've still got the king and all the government and all that. Still got the economy. It's just things have changed slightly. And in fact, one of the things I think changed and I explore this in the sequel after 1177 basically, is that they've lost their trading partners because that globalized network has broken down and some of the people with whom they had been interacting are now basically gone. Like they can't interact with the Hittites anymore because they're not there. There's no big Hittite king. Instead, what the Neo-Assurians do after it took them a little while to come back also, they do have drought there for a while, but when they bounce back by the 10th and certainly by the 9th century BC, like halfway through the Iron Age, the Neo-Assurians take over pretty much the entire ancient Near East. Basically all the areas they had been trading with and had commercial and diplomatic and marital ties back in the late Bronze Age, they've now just conquered. It's now part of the Neo-Assurian Empire that stretches all the way to the Mediterranean Sea and down to Egypt in fact at one point. So we see things change and we do now see empires growing again, but for a different reason. The Neo-Assurians are now taking what they need rather than trading for it. This is when we also begin to see the rise and fall of civilizations. I mean in Hamilton it talks about oceans, rise, empires, fall. That's basically what we've got here because yes, the Neo-Assurians rise up and they're dominant for a while, but then they go down and collapse and the Neo-Babylonians take over for a while and then they collapse in turn and we're often running with the Persians and then the Greeks and then the Romans and follow us up until today. But that's in part why I would again argue that the collapse of the late Bronze Age is so important and what happened after the collapse of the Bronze Age is perhaps even more important because it shows what happens if you are or not resilient, but it also set us on the path for what we've got today in the Western world. That is where everything comes from that we've got. I mean, yes, you can look back to Mesopotamia and Egypt and all that for some of the things that we've still got today, but out of the collapse of the late Bronze Age is going to come Greece, archaic and classical Greece with the invention of democracy and so on. So we're going to be on a, I wouldn't call it a straight path, but we can trace ourselves back to what happened 3,000 years ago to what we've got today. If we're ranking these societies as to how well they did in the aftermath of the collapse, I would put the Cypriots and the Phoenicians in the top category. They not only transform, but they're actually anti-fragile. Now, this is a phrase that Nicholas Nussim Taeleb has used. In fact, it's the title of one of his books. And what he says is that anti-fragile is something that actually flourishes in an age of chaos. It takes advantage of the chaos. So one might actually say, you know, collapse is not always terrible for everyone. For some people, it's an opportunity. And in this particular case, for example, we see the Phoenicians from Central Canaan. They spread out across the Mediterranean. One of my colleagues has called it a Phoenician Lake. They take advantage of the fact that Ugarit has been destroyed and that the navies of some of the others, like the Hittites and the Egyptians, have either been destroyed or are not what they once were. So I would say both the Cypriots and the Phoenicians are actually anti-fragile. They are flourishing in this age of chaos. They do better than anybody else. So I put them up in my top category. The Assyrians and the Babylonians, they adapt, but they don't really transform that much because they don't need to. They simply carry on as they were, but they are better than the Egyptians. For example, I would put the Egyptians in my category three. They are adapting a little bit, but more they're just kind of coping, if you will. They don't go down. They don't disappear. And in fact, that was one thing that I kind of changed from book one to book two and the end of book one. I was like, "Ooh, Egypt is the only one that really survived." And then book two, I'm a bit more nuanced. And like, no, actually there are others that survived better than Egypt. And I would put Egypt in the middle category three. They didn't do wonderfully, but they didn't do terribly. They're still there, but they have now withdrawn a bit from the international world because they are having problems back home, if I can put it that way. So this is into the third intermediate period, as Egyptologists call it. And at one point, we've got not just one, not just two, but three, and sometimes even four, people all saying that they are the pharaoh of Egypt at the same time, but in different areas of Egypt. Now, to my mind, that's not a good system. Egypt is supposed to be one king, one ruler, one country. And we look back to the new kingdom period, right? King Tut, Akhenaten, Amunhotep III. And so in comparison to the way it had been in what I would say is the glory days of the 14th and 13th centuries, Egypt in the 12th, 11th, 10th, 9th centuries is not even really comparable. But it's not terrible. And we do have some highlights. So for example, there's one guy Pusenes, who is known as the Silver Pharaoh. His tomb was found in 1939, right before World War II. If it had been found at any other time, it would have made worldwide headlines because it's, I believe, the second wealthiest tomb in Egypt just behind King Tut's. But most of the stuff in the tomb is silver rather than gold. So that's kind of a high point. We also have one of the pharaohs, a guy named Sheshank, Shishak of the Bible, probably. He's Libyan. He's the founder of the 22nd dynasty. And he actually tries to recreate the good old days, leaves us an inscription where he went up to Israel and Judah and campaigned up there. And may have even conquered, for example, Maggito, where we find an inscription with his cartouche up there. So it's not terrible in Egypt, but it's not like it used to be. One Egyptologist said to me, actually, when I gave a lecture there, that that's not a fair comparison, that it's like apples and oranges. And you can't compare third intermediate period to the new kingdom period. And I'm like, well, maybe not, but I'm comparing the iron aids to the Bronze Age in all the other societies. So I do think it's a fair comparison. But so it turned out what I said to them is, these categories I'm putting the societies in, ranking them one, two, three. I said, it's just my gut feeling based on everything that I've studied. But I'm not the be-all and end-all here, you want to present data that would persuade me to move them up or down. I'm quite happy to do that. So I will say now that you could put Egypt up in category two with the Syria and Babylon, and I'd still be able to sleep at night. But I'd also be quite happy to put them down into category four where they were like with the Mycenaeans and Minoans. So it's all fluid. And that's kind of the beauty of archaeology in ancient history is we put out a hypothesis, and then we try and test it, and then we go and excavate and find something completely new next week that makes us rearrange it. And that's all good. It's called science. That's how we advance. That's how we progress. But for now, I'm going to keep Egypt in category three. Category four, as I've just mentioned, is Minoans and Mycenaeans, they are just barely coping. They're not adapting. They're just coping. We see all the big palaces in mainland Greece. And even on Crete, for that matter, Mycenaeans, Pylos, or Comenos, Knoosos, they either are burned, invaded, internal rebellion, earthquake, you name it, they're all basically abandoned. And with them goes the writing system. Linear B, which we now know, is an early form of Greek. That ceases to be used by about 1050 BC, because it was only being used by the scribes in the palaces to create inventories. What came into the palace, what went out of the palace? Though surprisingly, they never mentioned overseas. The linear B never mentions contacts with Egypt or the Hidsites, whatever. It's a big problem, because I know from the archaeology that they are in contact. At any rate, what we would have called the Mycenaeans and Minoans, it comes crashing down. And as I've mentioned, they had to rebuild from the ground up. They do it successfully, but it takes quite a while. And that's why I end after 1177 BC with 776 BC, which is the first Olympics. And by that point, everything in Greece is back up and running, and we're very quickly going to get them using the new Greek alphabet. We're going to get Homer, we're going to get Hesiod, we'll get Sappho, we'll get the Archaic poets and Greece is off to the races. But it has taken 400 years. So I put them in my category four, because they did just about as badly as you could possibly do, and still survive. And then the last category, that's the Hittites. Don't be a Hittite. The Hittites do not do well at all. In part, because they've already got internal problems. We know that there was a schism in the royal family, and that one part moved. We also know that the Hittite capital city, Hatusas, was actually already abandoned before the end came, and that it was only partially destroyed afterward, and probably from people that otherwise had nothing to do with anything, the Kashka from the Northwest that had already destroyed Hatusas a couple hundred years earlier, they came back. So I think the Hittites probably did it to themselves anyway, though it certainly didn't hurt that the Sea Peoples were on the shores of Anatolia, and they would have been a primary example of the domino effect, and remember that the Hittites and Ugarit going down at the same time may have been what caused the collapse of absolutely everything. So I put the Hittites down there. I also put the Canaanites in southern Canaan into that lowest category, because we really don't see them again after the collapse of the Late Bronze Age. We do not refer to the Canaanites in the Iron Age by that name. We now call them by other names, the Judahites, the Israelites, the Ammonites, the Moabites, the Edomites. And so I'm of two minds. Either they were wiped out, or they assimilated. One of the two, and we've got both stories in the Hebrew Bible. Look at the book of Judges versus the book of Joshua, is it a genocide or is it a simulation? Either way, I don't think the Canaanites in southern Levant coped or adapted or transformed or anything like that. And so I put them down in my bottom category. On the other hand, if you were to argue, as some of my colleagues have done, that the Edomites, the Israelites, the Ammonites and all those guys are actually Canaanites who have transformed, then I would say, "Okay, in that case, this should be up in category two." Again, it's all flexible. I only put this out as a suggestion for what we might think about doing. And I fully expect that my suggestions hopefully will start the discussions rather than end it. I think that the new discoveries that we're making every day, every week, every month, every year, especially in biblical archaeology, are going to get us to alter things just like we've altered. Now what we think caused the late Bronze Age collapse will be able to fine-tune how everybody did in the aftermath. But I wanted to start the discussions. And I think they're pretty interesting discussions, which again, have some bearing on us today when we are grappling with some of the same things that brought down the late Bronze Age network and that the survivors had to deal with in the aftermath. When you look around today, we've got the same things here.
Want to support the channel? And the Big Think members community where you get access to videos early? Add free.